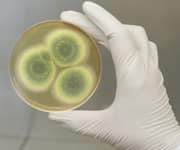

Life Extension Magazine®
Many think of probiotics and beneficial microorganisms only as related to gut health.
But bacteria on our skin are important contributors to dermatological health and appearance.1-3
Aging, overuse of facial cleansers, and anti-bacterial soaps, disrupt the delicate balance between good and bad bacteria on the skin.4,5
This contributes to premature skin aging.
Fermentation products of Aspergillus and the probiotic Lactobacillus produce substrates that have been shown to rebalance skin flora and promote DNA repair. The result is more youthful, vibrant skin.
The Skin Microbiota

The skin’s surface is home to diverse and complex microbial communities collectively known as the skin microbiota.6,7
Most of these bacteria work on our behalf.
Researchers are discovering their unique ability to provide an optimized inflammatory response that eradicates pathogens, mitigates harmful effects of sun exposure, and maintains a well-hydrated and intact barrier function.8-12
Aging, stress, and excessive washing create an imbalanced skin microbiome characterized by the depletion of good bacteria and multiplication of bad bacteria.13,14

What You Need to Know
Topical Skin Protection with Probiotic-Fermented Complex
-
The skin’s surface houses bacteria and other microorganisms collectively known as the skin microbiota.
-
Most of these bacteria are harmless and beneficial, protecting against infection, chronic inflammation, and barrier dysfunction.
-
Aging and excessive washing are among the numerous factors that cause an imbalance in the ratio of good to bad bacteria on the skin.
-
Lactobacillus ferment rebalances skin flora and produces anti-microbial peptides called bacteriocins that limit the growth of bad bacteria.
-
Aspergillus ferment is rich in proanthocyanidins that protect against and repair UV-induced DNA damage.
-
These anti-aging compounds have now been combined into one topical serum that promotes healthy, youthful skin.
Lactobacillus Ferment Rebalances Skin Flora
Scientists turned to one of the most well-recognized and proven probiotic bacterial groups, Lactobacillus, to rebalance an ailing skin microbiome.
Lactobacillus ferment promotes the growth of beneficial lactic acid bacteria. It also suppresses the colonization by pathogenic bacteria, through the synthesis of anti-microbial peptides called bacteriocins.15-18 In the laboratory, Lactobacillus ferment significantly reduced the reproduction of multiple bacterial species, including S. aureus associated with chronic inflammatory skin diseases.19-22
By limiting the growth of bad bacteria, while still allowing friendly bacteria to flourish, Lactobacillus ferment restores the skin flora to a healthy, balanced state. This, in turn, normalizes immune function and controls inflammation to help the skin regain youthful function and appearance.
Lactobacilli also synthesize free fatty acids during the fermentation process, which promotes a slightly acidic environment in the skin, conducive to anti-microbial defense, barrier function regeneration, and moisture retention.23
A recent clinical study showcased the hydrating properties of Lactobacillus ferment. When topically applied for four weeks, it was shown to increase participants’ skin moisture by 10% compared to baseline.22 This finding is noteworthy, as boosting moisture in the skin increases volume and fullness that diminishes the appearance of wrinkles and fine lines.
Let’s now look at how Aspergillus ferment protects against UV-induced damage to skin cells and supports DNA repair.
Aspergillus Ferment Promotes DNA Protection and Repair
Sun exposure generates a storm of destructive free radicals in the skin that cause cumulative DNA damage and contribute to the breakdown of structural proteins collagen and elastin, which ultimately leads to photoaging.24-27
Proanthocyanidins are polyphenols that combat UV-induced oxidative damage by blocking multiple inflammatory pathways and exerting potent antioxidant effects.28,29
Scientists discovered that Aspergillus ferment is rich in proanthocyanidins and can deliver greater concentrations of these beneficial compounds to the skin, and for a longer time period.30
As a result, Aspergillus ferment was shown to strengthen skin’s antioxidant protection, exhibiting greater suppression of free radicals than the well-known endogenous antioxidant superoxide dismutase (SOD).30
This effect completely protected skin cells from DNA damage under UV-radiated and non-radiated conditions. Aspergillus ferment also repaired existing sun damage by producing greater activation in DNA reparative processes compared to a control.30 These DNA-protective and DNA-repair effects lower skin cancer risk and increase the survival of healthy cells, to slow or even reverse cutaneous deterioration.
Summary
It’s becoming increasingly clear that an unbalanced cutaneous microbiota compromises optimal skin health and appearance.
Aspergillus and Lactobacillus ferment have been shown to bring the skin back into a healthy equilibrium, while inhibiting UV-induced damage and boosting advanced DNA repair.
This combination has now been formulated into one topical serum to create fresher, healthier, younger-looking skin.
Gary Goldfaden, MD, is a clinical dermatologist and lifetime member of the American Academy of Dermatology. He is the founder of Academy Dermatology in Hollywood, FL, and Cosmesis Skin Care. Dr. Goldfaden is a member of the Life Extension® Medical Advisory Board. All Cosmesis products are available online.
If you have any questions on the scientific content of this article, please call a Life Extension® Wellness Specialist at 1-866-864-3027.
References
- Byrd AL, Belkaid Y, Segre JA. The human skin microbiome. Nat Rev Microbiol. 2018 Mar;16(3):143-55.
- Christensen GJ, Bruggemann H. Bacterial skin commensals and their role as host guardians. Benef Microbes. 2014 Jun 1;5(2):201-15.
- Egert M, Simmering R. The Microbiota of the Human Skin. Adv Exp Med Biol. 2016;902:61-81.
- Shibagaki N, Suda W, Clavaud C, et al. Aging-related changes in the diversity of women’s skin microbiomes associated with oral bacteria. Sci Rep. 2017 Sep 5;7(1):10567.
- Yu JJ, Manus MB, Mueller O, et al. Antibacterial soap use impacts skin microbial communities in rural Madagascar. PLoS One. 2018;13(8):e0199899.
- Grice EA, Segre JA. The skin microbiome. Nat Rev Microbiol. 2011 Apr;9(4):244-53.
- Findley K, Grice EA. The skin microbiome: a focus on pathogens and their association with skin disease. PLoS Pathog. 2014 Oct;10(10):e1004436.
- Cogen AL, Yamasaki K, Sanchez KM, et al. Selective antimicrobial action is provided by phenol-soluble modulins derived from Staphylococcus epidermidis, a normal resident of the skin. J Invest Dermatol. 2010 Jan;130(1):192-200.
- Cogen AL, Yamasaki K, Muto J, et al. Staphylococcus epidermidis antimicrobial delta-toxin (phenol-soluble modulin-gamma) cooperates with host antimicrobial peptides to kill group A Streptococcus. PLoS One. 2010 Jan 5;5(1):e8557.
- Lai Y, Di Nardo A, Nakatsuji T, et al. Commensal bacteria regulate Toll-like receptor 3-dependent inflammation after skin injury. Nat Med. 2009 Dec;15(12):1377-82.
- Lai Y, Cogen AL, Radek KA, et al. Activation of TLR2 by a small molecule produced by Staphylococcus epidermidis increases antimicrobial defense against bacterial skin infections. J Invest Dermatol. 2010 Sep;130(9):2211-21.
- Patra V, Wagner K, Arulampalam V, et al. Skin Microbiome Modulates the Effect of Ultraviolet Radiation on Cellular Response and Immune Function. iScience. 2019 May 31;15:211-22.
- Wallen-Russell C. The Role of Every-Day Cosmetics in Altering the Skin Microbiome: A Study Using Biodiversity. Cosmetics. 2018;6(1):2.
- Prescott SL, Larcombe D-L, Logan AC, et al. The skin microbiome: impact of modern environments on skin ecology, barrier integrity, and systemic immune programming. The World Allergy Organization journal. 2017;10(1):29-.
- Perez RH, Zendo T, Sonomoto K. Novel bacteriocins from lactic acid bacteria (LAB): various structures and applications. Microb Cell Fact. 2014 Aug 29;13 Suppl 1:S3.
- Bastos MC, Ceotto H, Coelho ML, et al. Staphylococcal antimicrobial peptides: relevant properties and potential biotechnological applications. Curr Pharm Biotechnol. 2009 Jan;10(1):38-61.
- Cogen AL, Nizet V, Gallo RL. Skin microbiota: a source of disease or defence? Br J Dermatol. 2008 Mar;158(3):442-55.
- Bierbaum G, Gotz F, Peschel A, et al. The biosynthesis of the lantibiotics epidermin, gallidermin, Pep5 and epilancin K7. Antonie Van Leeuwenhoek. 1996 Feb;69(2):119-27.
- Totte JE, van der Feltz WT, Bode LG, et al. A systematic review and meta-analysis on Staphylococcus aureus carriage in psoriasis, acne and rosacea. Eur J Clin Microbiol Infect Dis. 2016 Jul;35(7):1069-77.
- Balci DD, Duran N, Ozer B, et al. High prevalence of Staphylococcus aureus cultivation and superantigen production in patients with psoriasis Eur J Dermatol. 2009 May-Jun;19(3):238-42.
- Fry L, Baker BS. Triggering psoriasis: the role of infections and medications. Clin Dermatol. 2007 Nov-Dec;25(6):606-15.
- Product Monograph: Leucidal® Liquid SF. Active Micro Technologies. 2019.
- Yadav H, Jain S, Sinha PR. Production of free fatty acids and conjugated linoleic acid in probiotic dahi containing Lactobacillus acidophilus and Lactobacillus casei during fermentation and storage. International Dairy Journal. 2007 2007/08/01/;17(8):1006-10.
- Emerit I. Free radicals and aging of the skin. EXS. 1992;62:328-41.
- Poljsak B, Dahmane R. Free radicals and extrinsic skin aging. Dermatol Res Pract. 2012;2012:135206.
- Fisher GJ. The pathophysiology of photoaging of the skin. Cutis. 2005 Feb;75(2 Suppl):5-8; discussion -9.
- Pandel R, Poljsak B, Godic A, et al. Skin photoaging and the role of antioxidants in its prevention. ISRN Dermatol. 2013 Sep 12;2013:930164.
- Mantena SK, Katiyar SK. Grape seed proanthocyanidins inhibit UV-radiation-induced oxidative stress and activation of MAPK and NF-kappaB signaling in human epidermal keratinocytes. Free Radic Biol Med. 2006 May 1;40(9):1603-14.
- Yang L, Xian D, Xiong X, et al. Proanthocyanidins against Oxidative Stress: From Molecular Mechanisms to Clinical Applications. Biomed Res Int. 2018;2018:8584136.
- Product Monograph: Nucleolys® DNA Protector. Green Tech. 2019.

